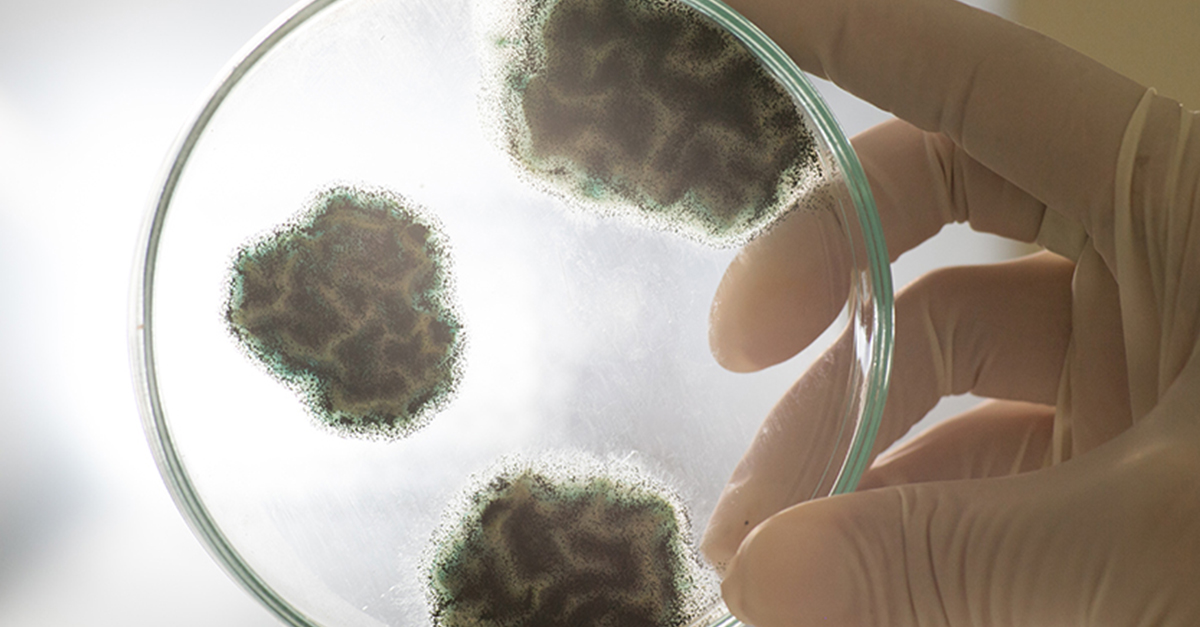

/wp-content/uploads/2018/01/p-Doopler_eko_ultrason_rontgen_1-1.mp4
Acil tıp, sağlık hizmetinin vazgeçilmez parçasıdır. Acil servisimizde petleriniz her zaman uzman bir hekim tarafından değerlendirilir. Kesintisiz laboratuvar ve... daha fazla oku

Profesyonel Pet Hospital kuaförleri petinizin tüy yapısına uygun istediğiniz her modelde kesim yapacaklardır, randevu almanız yeterli. Traşı biten petleriniz doktorlarımız tarafından genel muayenesinden... daha fazla oku

Acil tıp, sağlık hizmetinin vazgeçilmez parçasıdır. Acil servisimizde petleriniz her zaman uzman bir hekim tarafından değerlendirilir. Kesintisiz laboratuvar ve... daha fazla oku

Pet Hospital petlerde “Tüp Bebek” olarak bilinen “suni tohumlama” tekniğini Türkiye’de uygulayan ilk özel merkezdir. Aramızda, evlerimizde 15 yıldır... daha fazla oku

https://www.pethospital.com.tr/wp-content/uploads/2018/01/p-Tomografi_03_1.mp4
daha fazla oku

HAYVANLARIMIZDAKİ NÖROLOJİK HASTALIKLAR
Eskiden topların peşinden heyecanla koşan köpeğiniz artık ilgi göstermiyor ya da eskisi gibi çevik değil mi?
Koltuklara tırmanamıyor... daha fazla oku

Hastanemiz kapsamında her türlü cerrahi operatif girişimler uzman doktorlarımız tarafından yapılmaktadır. Operasyon öncesinde hastanın genel kontrolleri, laboratuar tetkikleri yapılıp... daha fazla oku

/wp-content/uploads/2018/01/p-Dis_Tedavi_unitesi_01_1.mp4
daha fazla oku

Kedi ve köpeklerde hastalıkların tanısında ve tedavisinde radikal bir yöntem olan endoskopik teşhis ve tedavi yöntemi Pet Hospital hekimlerince başarı ile... daha fazla oku

Hastanemizde ultrasonografik incelemeler için hitachi marka ultrasonografi cihazı kullanılmaktadır. Cihazımızla tüm abdolminal organlar görüntülenebildiği gibi cihazımızın M-moduyla da ekokardiyografi... daha fazla oku